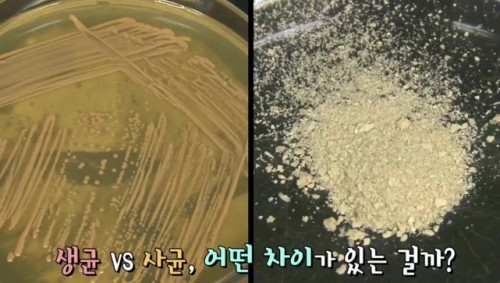

면역체계를 주제로 진행된 21일 방송에서는 대부분의 유산균이 장까지 도달하지 못하고 사라지는 점을 지적하며 최근 김치에서 추출한 유산균이 초미립자 열처리 과정을 거쳐 생성되는 유산균 nF1을 소개했다.
일반적으로 유산균은 장내 환경을 산성으로 만들어 유해균이 자라기 힘든 환경을 만들어준다.
따라서 대부분의 생균들은 사람의 위나 장에서 이미 그 기능을 상실한다.
반면 `장수 면역과 유산균 흡수율` 논문에 따르면 열처리를 거친 초미립자 nF1의 경우 사람 몸에 흡수될 수 있다.
쉽게 말해 유산균의 효능은 소장 내 흡수율과 밀접한 관계가 있는데 nF1은 보통의 유산균들과 달리 1마이크론 이하로 조정된 작은 크기의 사균체이기 때문에 소장에서의 흡수율이 우수한 것.
이날 방송에는 nF1을 비롯한 면역세포 보호에 도움을 주는 유산균에 대해 올바르게 섭취하고 있는지, 또 그 효과가 제대로 나타나는지에 대한 내용이 전파를탔다.
또 열처리 유산균 nF1을 다양한 음식 등에 첨가할 수 있는 김치유산균2000, 유산균바, 육수 등 제품군도 소개했다.
바이오제닉스코리아 관계자는 "이러한 제품들이 우리가 먹는 음식에 함유될 경우 면역력 증강 효과도 기대할 수 있다"며 "현재 nF1은 향후 식품과 관련한 대기업을 비롯해 요식업 프랜차이즈 등에서도 원료로 사용될 예정"이라고 말했다.
한편, 이번 방송은 홈페이지 다시 보기를 통해 시청할 수 있다.
국승한팀장 shkook@wowtv.co.kr
관련뉴스






